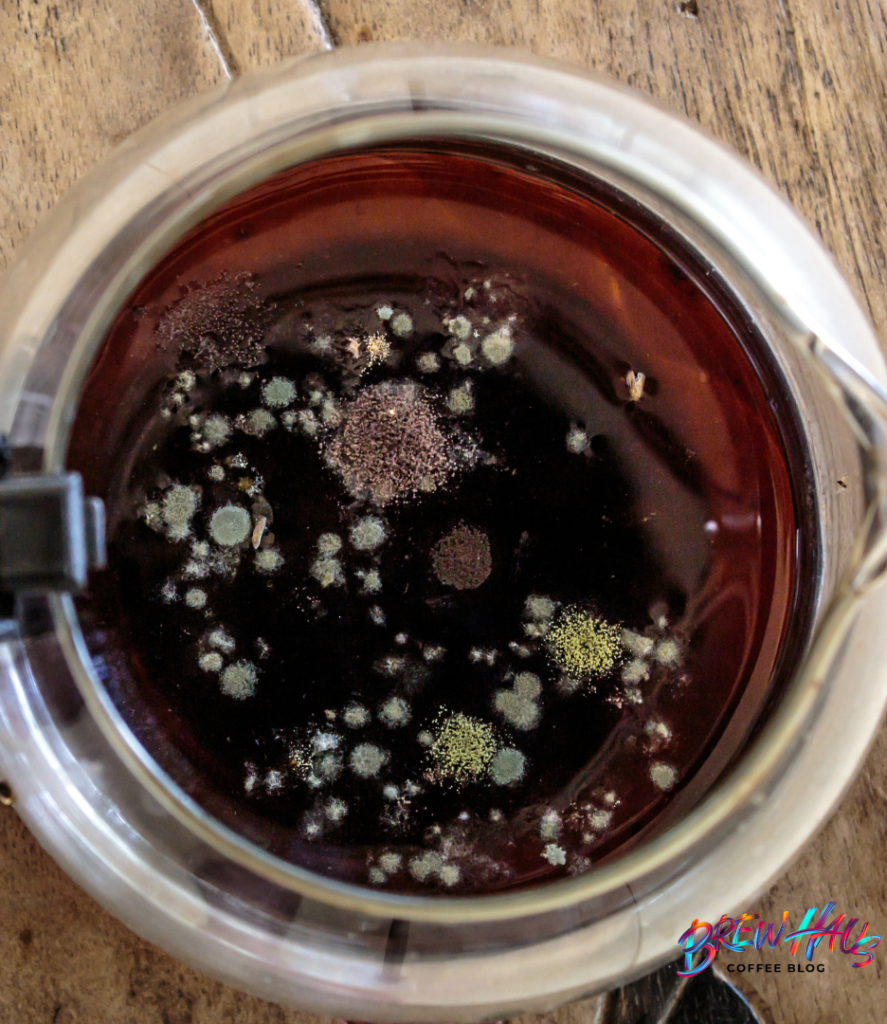
café con moho

Brewhaus Coffee Blog — por Javier Calderón Padilla
El Cold Brew es uno de los métodos de café más populares del mundo moderno, pero su historia es sorprendentemente antigua, viajando desde barcos mercantes japoneses hasta cafés hipster de tercera ola. Aunque hoy lo asociamos con frescura, notas dulces y baja acidez, el Cold Brew nació por necesidad, evolucionó por practicidad y se refinó gracias al café de especialidad.
Este artículo resume su origen, los riesgos que nadie habla lo suficiente, y una guía para hacerlo en casa de manera segura. Y como bonus Brewhaus, cerramos con uno de los primeros cafés fríos de la historia: el Mazagran, un clásico que vale la pena revivir.
Un poco de historia: el “café frío” más antiguo del mundo
Aunque existen varias teorías sobre los inicios del Cold Brew, la más documentada es el Kyoto-Style Coffee del siglo XVII.
Los mercantes holandeses preparaban extractos de café en frío en sus viajes porque duraban más tiempo sin dañarse, y se lo presentaron a los japoneses. Japón no solo lo adoptó: lo transformó en arte, creando torres de goteo lento que hoy son íconos elegantes y eficientes.
Más adelante, diferentes culturas incorporaron el café frío por razones prácticas:
Egipto y Argelia (siglo XIX): soldados franceses bebían café frío mezclado con limón para combatir el calor — ahí nace el Mazagran.
Estados Unidos (siglo XX): cafeterías lo usaban como concentrado para preparar grandes volúmenes rápida y consistentemente.
Tercera ola (2000–2020): se convierte en una opción sensorial, no solo práctica: más dulzura, menos acidez, más claridad y estabilidad.
Hoy, el Cold Brew es la evolución natural del café hacia la extracción selectiva y el disfrute sensorial.
¿Cómo funciona realmente el Cold Brew?
El Cold Brew es un método de extracción a baja temperatura (generalmente entre 4°C y 22°C) que se basa en:
Baja solubilidad → extracción lenta.
Menos ácidos volátiles → menor acidez percibida.
Alta estabilidad → dura más tiempo refrigerado.
Mayor cuerpo → más aceites permanecen en la bebida.
Sin embargo, las bajas temperaturas no inhiben del todo el crecimiento microbiano, y aquí es donde aparece el principal problema que suele ignorarse.
El lado oscuro: riesgos de contaminaciones y moho
A diferencia del café caliente, el Cold Brew sí puede desarrollar moho, levaduras y bacterias si se prepara o almacena incorrectamente.
Los riesgos principales son:
Tiempo prolongado a temperatura ambiente.
Equipos mal lavados.
Falta de filtración o filtración muy lenta.
Uso de agua sin la calidad adecuada.
🛑 Recordatorio crítico:
El Cold Brew no se deja reposar fuera de refrigeración sin una tapa hermética. Nunca.
Cómo hacerlo de forma segura (y deliciosa)
Proporción base (Brewhaus Standard)
Ratio 1/8 osea:
1 parte de café molido grueso
8 partes de agua fría filtrada
(Ej: 125 g de café + 1 L de agua)
Paso a paso
1. Preinfusión Brewhaus (hot bloom)
Agregue agua caliente (no hirviendo, 90–94°C) solo hasta humedecer la cama.
Espere 30–45 segundos.
Agregar el agua caliente nos ayuda en esto:
- elimina CO₂ atrapado
- acelera la extracción
- reduce el riesgo microbiano
- mejora claridad y dulzura
2. Agregá el resto del agua fría y remueva suavemente.
3. Refrigerar inmediatamente.
No dejes el café a temperatura ambiente sin una tapa hermética.
4. Extraé entre 12–16 horas según el perfil deseado.
5. Filtra muy bien.
Idealmente:
Filtración con filtro de papel.
6. Almacena en frío y consumí en 48–72 horas.
Más de 4 días es posible, pero no óptimo ni sensorial ni microbiológicamente.
5. Resultados que podés esperar
Un Cold Brew bien hecho te regala:
Dulzura natural marcada
Baja acidez
Cuerpo sedoso
Estabilidad sensorial
Versatilidad (concentrado, bebidas, cócteles, mocktails)
Pero, sobre todo: seguridad y limpieza, dos conceptos poco discutidos dentro de este método.
🔥Bono extra Brewhaus: Mazagran — El primer café frío del mundo (y cómo prepararlo en casa)

Si hablamos de café frío, no podemos cerrar el tema sin mencionar una de las bebidas más especiales, históricas y refrescantes que existen: el Mazagran. Considerado por muchos como el primer café frío moderno, nació en el siglo XIX en Argelia cuando soldados franceses, enfrentando calor extremo, mezclaban café fuerte con agua y limón para hidratarse sin perder energía. Con el tiempo, esta bebida cruzó el Mediterráneo y se volvió popular en cafés franceses.
Hoy, el Mazagran es una preparación perfecta para quienes buscan algo refrescante, brillante, sin azúcar ni lácteos, y con una historia que se disfruta tanto como el sabor.
Originalmente incluía:
- café fuerte
- agua fría
- limón
- a veces azúcar o menta
- servido en vaso alto, en mi caso un vaso para whisky.
Era refrescante, energético y fácil de preparar. El Mazagran es posiblemente uno de los primeros cafés fríos “funcionales” del mundo.
Aprovechando que ya tienes tu Cold Brew listo, aquí va la receta Brewhaus.
Receta Brewhaus del Mazagran
Ingredientes:
- 100 ml de Cold Brew concentrado
- 50 ml de agua fría o soda
- Jugo de ½ limón
- 1 oz sirope simple
- Hielo
- Rodaja de limón para decorar
Preparación:
1. Llene un vaso con hielo.
2. Mezcle el Cold Brew, el agua fría y el limón.
3. Endulce si quieres.
4. Sirve y disfrute el sabor de un café con historia.
Si eres amante del cold brew cuéntame en los comentarios su receta favorita, comparte este articulo a ese amigo/a que sabes que le encanta el café frío.
Fuentes
Heritage Coffee: Historia del Kyoto-Style Coffee.
“Cold Brew Coffee: Chemistry, Safety and Sensory Attributes”, Journal of Agricultural and Food Chemistry, 2017.
Smithsonian Magazine – historia del Mazagran.
